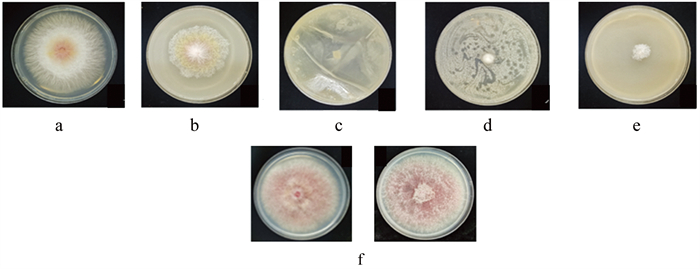

-
开放科学(资源服务)标识码(OSID):

-
沙棘是一种多年生落叶性灌木,广泛分布于欧亚大陆,我国从东北、华北到西北、西南地区均有大面积沙棘栽培和种植[1]。沙棘具有防风固沙、耐盐耐碱的特性,对我国生态环境建设具有重要意义[2]。沙棘果实中含有大量的营养物质,有着“维生素C之王”的美誉,很多大果沙棘品种的引进和栽培满足了人们对果品风味的更高要求[3]。
沙棘枯萎病又被称为沙棘干缩病或沙棘枝枯病,是一种沙棘的毁灭性病害,被称为“沙棘癌症”,严重降低了沙棘的寿命、果实的产量和品质[4]。早在1913年苏联就已经报道过沙棘枯萎病的发生,20世纪60年代病害在苏联大面积流行[4]。我国自20世纪90年代从俄罗斯引种大果沙棘品种,具有果实早熟、丰产等优点,主要在黑龙江、吉林和辽宁等省区作为小浆果栽培。然而,沙棘枯萎病的大面积发生一直严重制约着沙棘生态和经济产业的发展。最近研究表明,引起甘肃和黑龙江省沙棘枯萎病的病原菌为拟枝孢镰刀菌(Fusarium sporotrichioides)[4-5]。发病植株地上部叶片提前褪绿并大量脱落,在枝上形成凹陷病斑,随后病斑连结成片,整棵枝条干枯皱缩,严重感病的沙棘果实出现提早脱落的现象,最终导致沙棘林大面积死亡[6]。
目前针对沙棘枯萎病的防控策略主要是选育抗病品种和营造沙棘混交林,缺少防控药剂方面的系统性研究[7-10]。在前期研究基础上,选取沙棘枯萎病原菌拟枝孢镰刀菌为防控对象,采取室内平板对峙培养方法,利用目前获得农药登记的生物源杀菌剂对其开展室内药剂筛选,通过研究10种化学药剂和5种生物杀菌剂对拟枝孢镰刀菌室内菌丝生长的抑制作用,筛选出抑制效果较好的化学杀菌剂和生物杀菌剂。进一步通过盆栽试验,对室内筛选情况进行验证,为沙棘枯萎病的防控提供技术支持。
全文HTML
-
试验所用的拟枝孢镰刀菌(F. sporotrichioides)是分离自甘肃省沙棘种植基地的感病沙棘枝条,经分离、鉴定及致病性测定并鉴定为病原菌菌株(G1-5-1),现保存于沈阳农业大学植物保护学院[11]。试验于2019年7月~2020年7月在沈阳农业大学植物保护学院实验室和科研基地进行。
-
本试验所选用的10种化学杀菌剂和5种生物杀菌剂,原药保存在沈阳农业大学植物保护学院,药剂名称、有效成分及生产公司详见表 1及表 2。
-
试验所用的沙棘品种为大果沙棘,沙棘苗由辽宁旱地农林研究所提供。试验于2019年7月~2020年7月在沈阳农业大学植物保护学院实验室和科研基地进行。
-
在正式试验之前,首先进行预实验测定嘧菌酯悬浮剂、吡唑醚菌酯悬浮剂、咯菌腈悬浮剂、异菌脲悬浮剂、戊唑醇悬浮剂、百菌清可湿性粉剂、代森锰锌可湿性粉剂、甲基硫菌灵可湿性粉剂、多菌灵可湿性粉剂、氟哇唑乳油等10种化学杀菌剂对拟枝孢镰刀菌的作用浓度,经预试验后确定以上10种化学杀菌剂的处理浓度。
本试验采用生长速率测定法测定药剂对菌丝生长的抑制率[11-13]。将供试的10种化学杀菌剂用丙酮配制不同母液后,用无菌水将制剂稀释成不同浓度梯度:嘧菌酯悬浮剂为200、300、400、500、600 μg/mL;吡唑醚菌酯悬浮剂为24、48、96、192、348 μg/mL;咯菌腈悬浮剂为5、10、20、40、80 μg/mL;异菌脲悬浮剂为10、20、80、320、1280 μg/mL;戊唑醇悬浮剂为10、20、40、60、100 μg/mL;百菌清可湿性粉剂为25.6、51.2、102.4、204.8、409.6 μg/mL;代森锰锌可湿性粉剂为14.4、28.8、57.6、115.2、230.4 μg/mL;甲基硫菌灵可湿性粉剂为40、60、80、100、120 μg/mL;多菌灵可湿性粉剂为20、40、80、160、320 μg/mL;氟哇唑乳油为1、2、4、6、12 μg/mL。提前配制好的PDA培养基冷却至50 ℃,将供试10种化学杀菌剂不同浓度的母液分别用无菌水稀释至10 mL,将其均匀混入90 mL已冷却至45 ℃左右的PDA培养基中,配制成供试药剂的最终浓度梯度后制成供试平板。将等体积10 mL无菌水加入PDA培养基中作为空白对照,每组浓度设置3个重复。待培养基冷却后,使用无菌打孔器在菌落边缘取下0.5 cm大小的菌饼接种在所处理的培养基上,25 ℃条件下恒温培养7 d,用十字交叉法测量菌落直径。
-
依据生物杀菌剂推荐使用浓度,将供试的5种生物杀菌剂分别用无菌水配制成1 mg/mL的供试药液10 mL,将其均匀混入90 mL冷却至45 ℃左右的PDA培养基中,制成供试生物杀菌剂浓度为0.1 mg/mL的平板。在纯化培养的拟枝孢镰刀菌菌丝边缘,用灭菌打孔器取5 mm直径的菌饼接于含药平板中央,菌丝直接接触含药培养基,每个处理4次重复,置于25 ℃生化培养箱中培养。每隔24 h采用十字交叉法测量各处理的菌落生长直径。
按如下公式计算菌落生长抑制率:
-
杀菌剂盆栽筛选:将健康沙棘枝条栽植在装有2 kg无菌土的花盆里,每盆栽2棵,每4 d向花盆里浇1次水,并浇灌霍格兰营养液促进沙棘生根。待长出6~10片叶片,对盆栽苗木进行病原菌的接种。接种方法:使用灭菌后的竹签对根部进行伤根处理,每盆随机刺伤10次,用浓度为1×106个/mL的拟枝孢镰刀菌孢子悬浮液进行接种,每盆接种50 mL孢子悬浮液,同时以清水处理作为对照。根据前期预实验结果,排除对沙棘有不良影响的化学杀菌剂浓度。
盆栽试验依据10种化学杀菌剂的推荐使用剂量,分别为:25%嘧菌酯悬浮剂(1 000倍液)、30%吡唑醚菌酯悬浮剂(1 000倍液)、2.5%咯菌腈悬浮剂(1 000倍液)、50%异菌脲悬浮剂(1 000倍液)、43%戊唑醇悬浮剂(1 000倍液)、75%百菌清可湿性粉剂(1 000倍液)、80%代森锰锌可湿性粉剂(2 000倍液)、70%甲基硫菌灵可湿性粉剂(2 000倍液)、50%多菌灵可湿性粉剂(2 000倍液)、40%氟哇唑乳油(1 000倍液)。
接种14 d后,对接种植株进行第1次施药,施药方法为灌根施药,每盆的灌根用药量为500 mL/次。第1次施药20 d后进行第2次施药,每种药剂分别处理10盆(20棵沙棘植株),施药时间选择在下午进行。第2次用药后10 d进行病情调查。
生物制剂盆栽筛选:将健康沙棘枝栽培在装有2 kg无菌土的花盆里,每4 d向花盆里喷淋一次生物杀菌剂(800倍液),共施用2次,每次施用500 mL,期间浇灌1次500 mL霍格兰营养液促进沙棘生根。待长出6~10片叶片,对盆栽苗木进行病原菌的接种,接种方法同上,接种后第14 d开始灌根,施用1次生物杀菌剂,之后连续施用2次,接种后共施用3次生物杀菌剂,每次间隔7 d。接种后每次施用生物杀菌剂浓度为500倍液,每盆施用500 mL,同时以清水处理作为对照。每种生物杀菌剂处理20株沙棘植株,第3次施药后10 d进行病情调查。
病害分级标准如下[4]:
0级:健康无病;
1级:1/3枝条上出现叶片黄化、萎蔫;
2级:1/3~1/2枝条上叶片黄化、萎蔫,或枝条上出现凹陷病斑;
3级:1/2~3/4叶片黄化、萎蔫或脱落,或病斑连结成片;
4级:3/4以上的枝条落叶,枝条干枯,皱缩。
药剂防效计算方法:
-
采用SPSS 16.0中单因素方差分析(one-way ANOVA)和Duncan氏多重比较进行各化学杀菌剂对病原菌丝抑制生长率的差异显著性分析。采用SPSS 16.0软件进行室内毒力测试数据统计,计算各化学杀菌剂有效抑制中浓度(EC50)、95%置信区间、卡方值等相关参数。
1.1. 供试菌株
1.2. 供试药剂
1.3. 供试沙棘品种
1.4. 室内抑菌率测定与筛选
1.4.1. 化学杀菌剂抑菌率测定
1.4.2. 生物杀菌剂抑制率测定
1.5. 化学杀菌剂和生物制剂盆栽药效筛选应用试验
1.6. 数据处理与分析
-
进行抑菌试验的测定之前,对10种化学杀菌剂分别进行不同浓度处理,如表 3所示,培养7 d后,含几种化学杀菌剂的PDA培养基对拟枝孢镰刀菌菌丝生长均具有一定的抑制效果。从菌丝生长情况来看(图 1),当代森锰锌可湿性粉剂的浓度为2 304 μg/mL时,其抑制效果最好,菌落平均直径为0.67 cm;其次为多菌灵可湿性粉剂,当其浓度为3 200 μg/mL时,其菌落平均直径为0.71 cm。
菌丝生长抑制率结果表明,10种供试化学杀菌剂的抑菌效果均随其浓度的增加而增加。浓度为2 304 μg/mL的代森锰锌可湿性粉剂与浓度为3 200 μg/mL的多菌灵可湿性粉剂的菌丝生长抑制率明显高于其他8种不同浓度的化学杀菌剂。其中代森锰锌可湿性粉剂在浓度为2 304 μg/mL时,其抑制效果最好,达到97.7%,浓度为144~2 304 μg/mL时菌丝生长抑制率存在显著性差异。多菌灵可湿性粉剂在浓度为3 200 μg/mL时菌丝生长抑制率达到97.2%,其浓度为400~3 200 μg/mL时,菌丝生长差异性不显著。
-
根据供试菌饼在10种含药PDA培养基上菌落平均直径的大小计算出抑制率,求得各种化学杀菌剂对拟枝孢镰刀菌的毒力(表 4)。氟哇唑乳油对拟枝孢镰刀菌菌丝的毒力最好,EC50值为13.089 μg/mL;其次为咯菌腈悬浮剂,EC50值为51.732 μg/mL;代森锰锌可湿性粉剂、戊唑醇悬浮剂、多菌灵可湿性粉剂的毒力效果也比较好,EC50值分别为114.202 μg/mL、120.178 μg/mL和135.274 μg/mL。在10种供试化学杀菌剂中,嘧菌酯悬浮剂对拟枝孢镰刀菌的毒力较低,EC50值为895.945 μg/mL。10种化学杀菌剂的相关系数为0.979~1.000,该结果表明,供试10种化学杀菌剂的抑制作用与化学杀菌剂的浓度呈正相关。
-
采用室内菌丝生长速率测定法,根据菌丝生长情况(图 2)筛选出对拟枝孢镰刀菌抑制效果较好的生物杀菌剂,分别为抗重茬微生物制剂、绿康威微生物菌剂、105亿/g多黏菌·枯草芽孢杆菌可湿性粉剂(药剂浓度0.1 mg/mL)。中生菌素的抑菌效果较差。
根据上述公式计算出5种供试生物杀菌剂对供试菌饼的抑制率(表 5),抑制效果由高到低依次为:抗重茬微生物制剂>绿康威微生物菌剂>105亿/g多黏菌·枯草芽孢杆菌可湿性粉剂>海洋菌制剂>5%中生菌素。
-
接种病原菌的沙棘植株在10种化学杀菌剂处理后的发病率与对照相比均有下降,结果如表 6所示。代森锰锌可湿性粉剂防控后沙棘的发病率最低,防效达到82.3%;其次为氟哇唑乳油,防效为74.9%;戊唑醇悬浮剂的防效为71.2%;甲基硫菌灵可湿性粉剂的防效为65.4%;多菌灵可湿性粉剂的防效为61.5%;异菌脲悬浮剂的防效最低,仅为23.1%。
-
温室盆栽试验表明(表 7),在沙棘扦插前喷淋800倍液抗重茬微生物制剂,扦插后用500倍液抗重茬微生物制剂灌根取得的防控效果最佳,防控效果达到了67.8%;沙棘扦插前喷淋800倍液绿康威微生物菌剂,扦插后用500倍液绿康威微生物菌剂灌根的防控效果也比较好,防效达到了65.6%。应用105亿多黏菌·枯草芽孢杆菌可湿性粉剂进行盆栽试验也取得了57.0%的防控效果。
2.1. 室内药剂筛选
2.1.1. 室内化学杀菌剂筛选
2.1.2. 室内不同化学杀菌剂对拟枝孢镰刀菌的毒力比较
2.1.3. 室内生物杀菌剂筛选
2.2. 沙棘枯萎病的盆栽药剂防效试验
2.2.1. 10种化学杀菌剂对沙棘枯萎病的盆栽防效
2.2.2. 5种生物杀菌剂对沙棘枯萎病的盆栽防效
-
沙棘枯萎病是沙棘生产上遇到的较难防治的病害,常被称作“沙棘的癌症”,发生严重时可造成整片沙棘种植园的毁园[10-14]。由于缺乏免疫品种,化学防治和生物防治仍是主要的防治措施,丙环唑微乳剂、百菌清可湿性粉剂、丙环唑乳油、红日和恶霉灵等对沙棘枯萎病菌都有一定的抑制作用[13-17]。丙环唑乳油和百菌清可湿性粉剂是生产上的常规化学杀菌剂,防治效率高,杀菌谱广,残效期长,可有效防治果树、蔬菜和禾本科等作物上多种真菌引起的病害[16]。本次研究结果表明,氟哇唑乳油对致病菌的毒力最好,EC50值为13.089 μg/mL;其次为咯菌腈悬浮剂,EC50值为51.732 μg/mL;代森锰锌可湿性粉剂、戊唑醇悬浮剂、多菌灵可湿性粉剂对该菌抑制效果良好,其EC50值分别为114.202 μg/mL、120.178 μg/mL和135.274 μg/mL。10种供试化学杀菌剂中,嘧菌酯悬浮剂EC50值为895.945 μg/mL,在盆栽试验中的防控效果较差。10种化学杀菌剂对沙棘枯萎病的盆栽防效表明,代森锰锌可湿性粉剂、氟哇唑乳油、戊唑醇悬浮剂、甲基硫菌灵可湿性粉剂和多菌灵可湿性粉剂对沙棘枯萎病的防控效果较好,防效分别达到了82.3%、74.9%、71.2%、65.4%、61.5%。综合化学杀菌剂在室内对拟枝孢镰刀菌的抑菌效果和毒力与盆栽试验比较的结果,代森锰锌可湿性粉剂、氟哇唑乳油、戊唑醇悬浮剂、甲基硫菌灵可湿性粉剂和多菌灵可湿性粉剂对沙棘枯萎病具有较好的防控潜力和应用前景。
关于镰刀菌引起的枯萎病防治最新报道,Tyagi R等[18]采用定制化的合成微生物群落(SMC),并通过先进的筛选技术确保菌株间的协同增效,最终获得了一个高效、稳定且环境友好的木豆镰刀菌枯萎病生物防治方案。Yu等[19]利用健康植株根际富集的有益菌属来构建并简化合成微生物群落,是一种极其有效的策略,能够高效防控由尖孢镰刀菌引起的西瓜枯萎病,为绿色农业提供了新的方向。Liu等[20]研究发现,山梨酸钾与贝莱斯芽孢杆菌EB1可协同使用,为实现香蕉枯萎病的可持续绿色防控提供了一种行之有效的新方案。
目前,我国针对沙棘枯萎病的防治主要是化学防治,化学防治虽然表现出一定的防治效果,但是容易造成病原菌的抗药性,且会造成残留,对生态环境不够友好,在我国倡导实行的“绿色防控”植物保护方针下,应该开发新型的生物防治方法来防控沙棘枯萎病。前人采用菌株对峙培养法和非挥发性代谢产物对病原菌生长抑制法,对引进木霉菌株T43及其抑菌活性物质对沙棘干缩病病原菌拟枝孢镰刀菌的抑制效果进行研究,木霉菌株T43对沙棘枯萎病菌的抑制率为44%[21-22]。邓龙[23]在室内对峙培养中筛选出菌株Alternaria tenuis和菌株Fusarium chlamydosporum,其对病原菌拮抗作用显著,菌株Trichoderma atroviride对病原菌也有较好的拮抗作用。本研究通过室内筛选试验表明,5种活菌型生物杀菌剂均有一定的抑菌作用,但不同生物杀菌剂的抑菌效果具有较大的差别:抗重茬微生物制剂的抑制率达到99.6%,绿康威微生物菌剂的抑制率达到97.8%,105亿/g多黏菌·枯草芽孢杆菌可湿性粉剂的抑制率为82.6%;5%中生菌素的抑制率仅为21.8%,这是有益微生物对不同病原菌抑制作用的特异性所导致的[17]。盆栽试验的结果和室内抑菌试验的结果一致,3种室内抑菌效果较好的生物杀菌剂都取得了比较好的防控效果,防效分别达到了67.8%、65.6%、57.0%。有研究表明绿康威和绿康地3号与化学药剂交替施用与单独施用化学药剂的防效相当,且该试验中2种微生态制剂与化学药剂交替施用使化学药剂施用量减少35%,为化学药剂的减量找到了具体有效的途径[24-25]。抗重茬微生物制剂和绿康威微生物菌剂的联合使用对尖孢镰刀菌(Fusarium oxysporum)引起的辣椒枯萎病有较好的防控效果,田间防效达到了72.2%[26]。结合本次的研究结果,绿康威微生物菌剂、多黏菌·枯草芽孢杆菌可湿性粉剂和抗重茬微生物制剂等生物杀菌剂中的有益微生物对沙棘枯萎病的致病菌拟枝孢镰刀菌具有较好的抑制作用。最近的报道中发现,辽宁省朝阳地区沙棘枯萎病的病原菌为层出镰刀菌[27],这为该病害的防控提出了新的挑战。随着对沙棘枯萎病病原学的进一步研究,将有助于人们对该病害复杂性的认识。本次试验仍存在着一定的局限性,仍需连续多年开展沙棘枯萎病的田间药剂防控研究,筛选出具有稳定防效的化学杀菌剂和生物杀菌剂,为沙棘枯萎病的防控提供技术支持。




 下载:
下载: